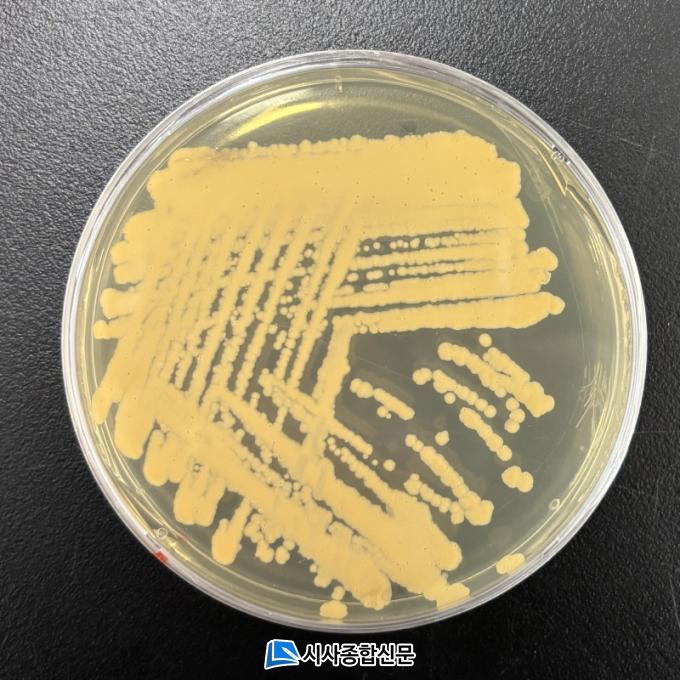

À̹ø¿¡ ¹ß°ßµÈ ¼¼±Õ ¡®·ÎµµÄÚÄ¿½º Ť¼ÑÁö(Çиí: Rhodococcus qingshengii)¡¯´Â ³²Á¶·ù¿¡¼ ºÐºñµÇ´Â µ¶¼ÒÀÎ ¸¶ÀÌÅ©·Î½Ã½ºÆ¾À» ºÐÇØÇϴ Ư¡À» °®°í ÀÖ´Ù. ¸¶ÀÌÅ©·Î½Ã½ºÆ¾Àº ƯÁ¤ ³²Á¶·ù°¡ ºÐºñÇÏ´Â ´ëÇ¥Àû µ¶¼Ò·Î, ÀÎü ¹ß¾Ï¼º ¹°Áú·Î ¾Ë·ÁÁ® ÀÖ´Ù.
ÀÌ µ¶¼Ò´Â ½Ä¼ö¿øÀ¸·Î »ç¿ëµÇ´Â °, È£¼ö, Àú¼öÁö µî ´Ù¾çÇÑ ¼ö¿ª¿¡¼ °ËÃâµÇ¸ç, ÇØ¿Ü¿¡¼´Â µ¿¹° Áý´Ü Æó»çÀÇ ¿øÀÎÀ¸·Îµµ º¸°íµÇ°í ÀÖ´Ù.
¿¬±¸ÁøÀº ÀÌ ±ÕÁÖ¸¦ Ȱ¿ëÇÑ ½ÇÇèÀ» ÅëÇØ, ÇØ´ç ¼¼±ÕÀÇ µ¶¼Ò ºÐÇØ ´É·ÂÀº ÀÏÀÏ 486.8¥ìg/LÀ̸ç, À̴ ǥÁرÕÁÖ ´ëºñ 20¹è ÀÌ»ó ³ôÀº ºÐÇØ ´É·Â¿¡ ÇØ´çÇÏ´Â °ÍÀ» ¹àÇô³Â´Ù. ¶ÇÇÑ, ÀÌ ¼¼±ÕÀÌ »ýÅÂ°è ³» ´Ù¾çÇÑ ¹Ì»ý¹° ¹× ¼ö»ý »ý¹°ÀÇ ¼ºÀåÀ» ÀúÇØÇÏÁö ¾Ê°íµµ µ¶¼º ¹°ÁúÀ» Á¦°ÅÇÒ ¼ö ÀÖ¾î, 2Â÷ ¿À¿°À̳ª »ýÅÂ°è ±³¶õÀ» ÃÖ¼ÒÈÇϴ ģȯ°æÀû ÇØ°áÃ¥À» Á¦½ÃÇÒ ¼ö ÀÖÀ» °ÍÀ̶ó ±â´ëÇϰí ÀÖ´Ù.
ÃÖ°æ¹Î µµ¼»ý¹°À¶ÇÕ¿¬±¸½ÇÀåÀº ¡°±âÈĺ¯È·Î ÀÎÇØ À¯ÇØ ³²Á¶·ù µ¶¼Ò ¹®Á¦°¡ ½ÉȵǴ °¡¿îµ¥, À̹ø ¿¬±¸¼º°ú´Â »ý¹°ÀÚ¿ø ±â¼úÀ» ÅëÇØ ±¹¹Î °Ç° ÁõÁø¿¡ ±â¿©ÇÒ ¼ö ÀÖ´Â ¹æ¾ÈÀ» Á¦½ÃÇÑ´Ù´Â Á¡¿¡¼ Àǹ̰¡ Å©´Ù¡±¶ó¸ç ¡°¾ÕÀ¸·Îµµ ¾ÈÁ¤ÀûÀ̰í Áö¼Ó °¡´ÉÇÑ »ý¹°ÀÚ¿ø Ȱ¿ë ±â¼ú °³¹ßÀ» À§ÇØ ÃÖ¼±À» ´ÙÇϰڴ١±¶ó°í ¹àÇû´Ù.


2026.02.16 (¿ù) 22:36